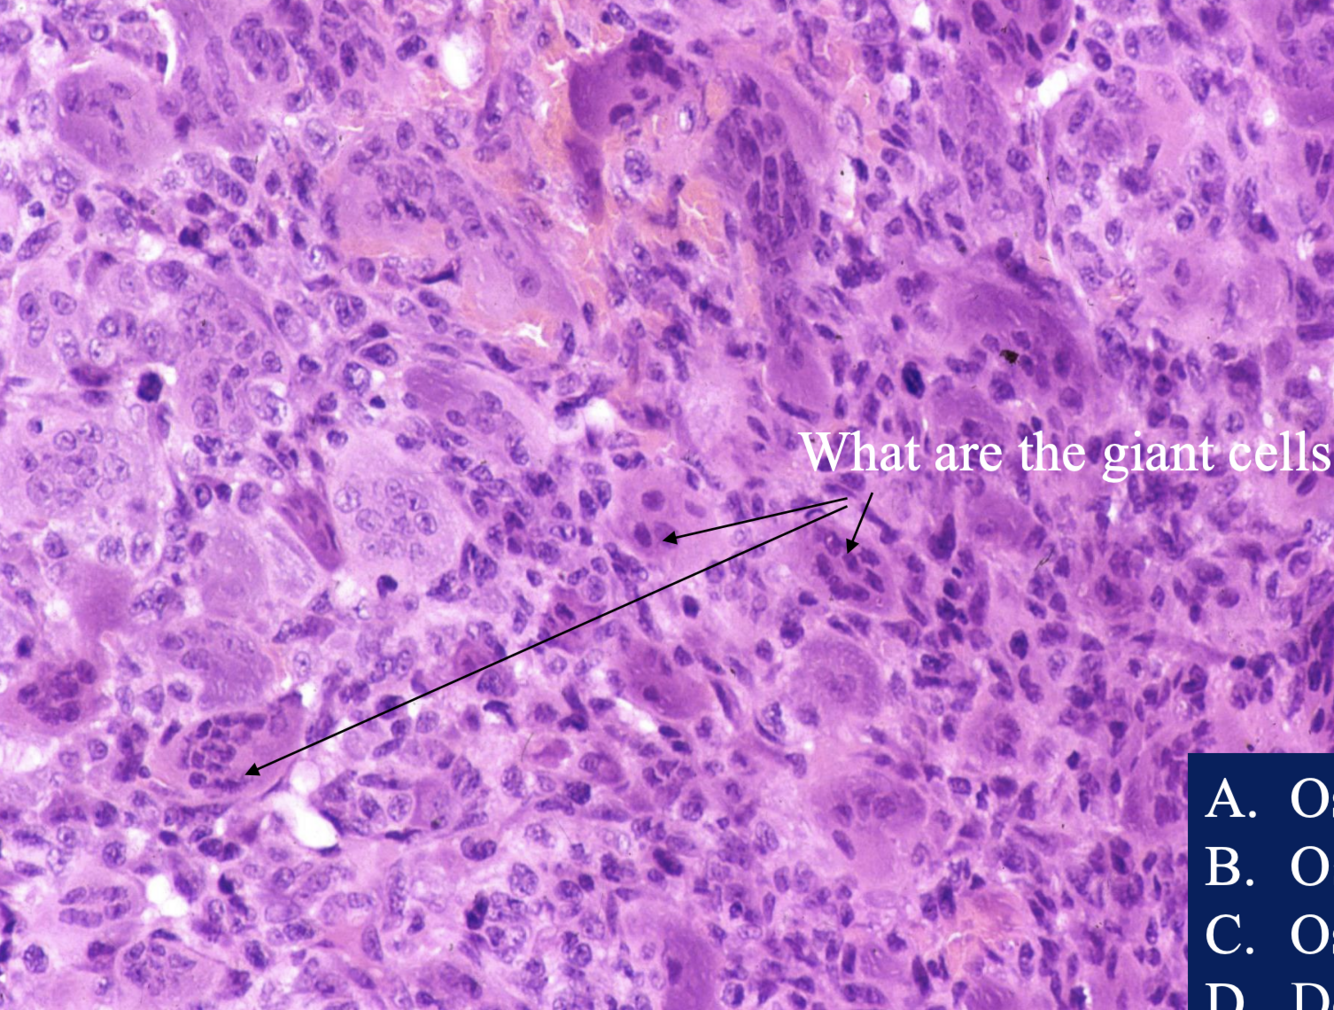

What is a sarcoma?
Malignant Connective tissue tumor
What is the eipdemiology of malignant bone tumours?
Generally young adults/chidlren
What is the most common site of bone tumours?
Generally around knee, but different for different types of tumours
What is the initial investigation in an suspected bone tumour?
What are the expected findings?
X-Ray
- Lytic features
- extention of bone into soft tssue
What is the gold-standard for diagnosis of sarcomas?
Biopsy
- core Needle biopsy under radiological guidance
What are differentials for bone tumours?
- fibrous dysplasia
- Metaphyseal fibrous cortical defect
What is fibrous dysplasia?
Genetic mutation causing fibrous, weak tissues being layed down instead of mature bone

What is the epidemiology of Fibrous dysplasia
Usually F>M (because of McCune Albright syndrome is 10:1 F:M)
Presentation
- <10 if McCUne Albright syndrome (polyostic)
- 20-30 if single bone involved

What is McCune Albright syndrome?
A genetic syndrome caused by a G-protein activating mutation and subsequent continuous stimulation of endocrine functions
Causes Café au lait spots, fibrous dysplasia + endocrine dysfunctions

What is the commonest site of lesions in Fibrous dysplasia?
Can be any bone
More common
- Rib + proximal femur

X-ray shows a soap bubble osteolysis and Shepherd’s crook deformity - what disease is it likely to be?
Fibrous dysplasia
Shepherd’s crook deformity: coxa varus angulation of the proximal femur, classically seen in femoral involvement

A Bone histology shows chinese letters - what is the likely diagnosis going to be?
Fibrous dysplasia

What is an osteochrondroma?
Benign bone and Cartilage tumour
Most common benign bone tumours
What is the preferred site of osteochondroma?

Bone histology of a lesions shows
Cartilage capped “mushroom” bony outgrowth - what is the diangosis?
Osteochondroma
Show’s normal bone covered by cartilage

What is and enchondroma?
Benign tumour originatign from cartilage
What is the most common site for Enchondromas?
Usually presents in Hands (45%)
What does histology of an enchondroma show?
Normal cartilage
Calcified matrix

X-ray shows a Lytic lesion
Cotton wool calcification
Expansile and O ring sign - what is the likely diagnosis?
Enchondroma
Can overall look malignant on X-ray

What is a Giant Cell tumour?
What is the epidemiology?
It is a borderline-malignant tumour (of bone, derived from the bone marrow) (usually locally agressive, but even though can metastasise, does not have to)
Usually in 20-40yo
F>M
What are histological findings of a Giant cell tumour?
Osteoclasts and stromal cells (stromal cells are the malignant cells, but many osteoclasts giant cells seen)
“Soap bubble appearance”
“Giant multi-nucleate osteoclasts (Arrow)
What is the x-ray appearance of a giant cell tumour?
Lytic/lucent lesions right up to articular surface (usually non-invasive)

What is the usual distribution of metastatis bond tumours?
Usually do not go below the elbow or below the knee
It depends on the age group + primary malignancy
What is the site distribution of Giant cell tumour?
Commonest Knee-epiphesis











